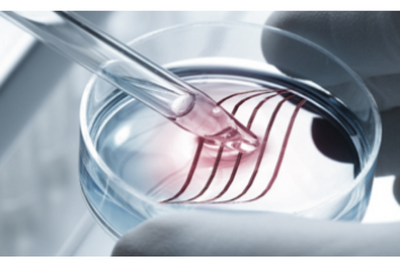

- Gene Expression Analysis
- Genotyping
- Next Generation Sequencing
- Biomarker Analysis
- miRNA Research
- Cloning
- Nucleic Acid Purification
- Antigens and Antibodies
- Molecular Reagents
Bioline
Gene Expression Analysis
Gene expression analyses study the occurrence or activity of the formation of a gene product from its coding gene. It is a sensitive indicator of biological activity wherein a changing gene expression pattern is reflected in a change of biological process. Gene expression profiling goes beyond the static information of the genome sequence into a dynamic functional view of an organism's biology and is a widely used approach in research, clinical and pharmaceutical settings to better understand individual genes, gene pathways, or greater gene activity profiles. Gene expression analysis can be achieved through a variety of means, however real-time PCR has risen as the most popularly used approach and the range of products in the Meridian portfolio are well placed to support these studies.
Real-Time PCR Kits - One-Step RT-qPCR
Genotyping

Since Mendel first established the concept of genetic inheritance and the genotype-phenotype connection, scientists have sought to understand and map genetic variation in humans and across a range of other species. There are a number of approaches to genotyping, including analysis of single nucleotide polymorphisms (SNPs), variation of long or short tandem repeats and other DNA fingerprinting methods. Large databases have been amassed to record and share genotyping information and efforts continue to ultimately link variation to the presence of specific traits or disease states. In many instances, however, phenotype and subsequent inheritance is proving to be a more complex story. Genotyping information, however, is still a useful part of the picture and whether this information is gained through PCR, real-time PCR or sequencing methods, Meridian has the right tool to support your research.
Next Generation Sequencing

Massively parallel sequencing technology, termed next generation sequencing (NGS), has transformed biological research, offering an unparalleled level of data collection, invigorating the field of genomics and revolutionizing the potential for understanding our genetic basis. As access to technology increases and costs become more affordable, NGS-based research and applications will continue to grow.
Biomarker Analysis

The presence of nucleic acids in serum and other biological fluids has long been recognized. Efforts to use these elements as biological markers, or biomarkers, are attractive due to the accessibility of biofluids and the potential of biomarkers to provide useful, reproducible and objective information on the normal or pathological state of a biological process. Tools that can efficiently isolate nucleic acids from biofluids, along with assays, kits or panels that can interrogate nucleic acid content are all supplied by Meridian , with an ISO 13485 level of manufacturing that offers the quality required to move research efforts towards successful application.
Real-Time PCR Kits for Fast qPCR and Two-Step RT-qPCR
Real-Time PCR Kits for Standard qPCR and Two-Step RT-qPCR
Real-Time PCR Kits for Fast One-Step RT-qPCR
miRNA Research

Since their discovery a little over 20 years ago, miRNAs have emerged as an exciting and promising research and applied science target due to their involvement in many important cellular processes and their clear links to disease states. Meridian has developed a range of products to support miRNA research, including a range of expertly designed qPCR panels for analyzing important miRNAs in the areas of cancer, stem cells and biofluid analysis.
Real-Time PCR Kits for Fast qPCR and Two-Step RT-qPCR
Real-Time PCR Kits for Standard qPCR and Two-Step RT-qPCR
Real-Time PCR Kits for Fast One-Step RT-qPCR
Cloning

Gene cloning and vector construction are some of the most frequently used techniques in molecular biology. Short DNA fragments or whole genes are inserted into plasmids or virus chromosomes, replicated in a bacterial or eukaryotic host and subsequently isolated allowing for downstream sequencing/characterization of the gene of interest, or study of gene expression/protein production. Whatever your requirements, Meridian has an extensive range of cloning reagents to expertly prepare your targets plus a selection of competent cells to suit your specific application, all offering efficient transformation with rigorous quality control for reproducible results.
Nucleic Acid Purification

Studying the complex details of the biological world requires the use of tools that allow effective and sensitive isolation of the individual elements that make up these systems. Almost every molecular biology workflow starts with an extraction step to isolate the target molecule(s) (DNA, RNA, protein) of interest for the downstream applications of purification, amplification, or manipulation. Meridian offers a suite of specially formulated nucleic acid purification reagents to provide streamlined, sensitive and robust options for this routine, yet highly important step of your workflow.
Antigens and Antibodies
Diagnostic assays that deliver the best patient outcomes rely on high-quality reagents. Meridian offers diagnostic manufacturers the complete solution with over 3,000 antigens and antibodies covering more than 500 disease targets and an extensive range of specialty qPCR master mixes and molecular enzymes manufactured under ISO13485 regulations. Meridian offers diagnostic manufacturers the complete solution.

- Respiratory Diseases
- Gastrointestinal Pathogens
- Sexually Transmitted Diseases (STDs)
- ToRCH & Childhood
- Viral Hepatitis
- Tropical & Vector-Borne Diseases
- Hormones & Steroids
- Cardiac, Cholesterol, & Metabolic Markers
- Cancer Markers
- Blockers & Immunoglobulins
- Renal Diseases
- Autoimmune
- Neurological Diseases & Trauma
- DOA
- Allergens
- Food & Water Testing
- Antimicrobial Resistance
- Microbial Detection
- Vet Health
- Toxins & Biowarfare
- Miscellaneous Reagents
Molecular Reagents

